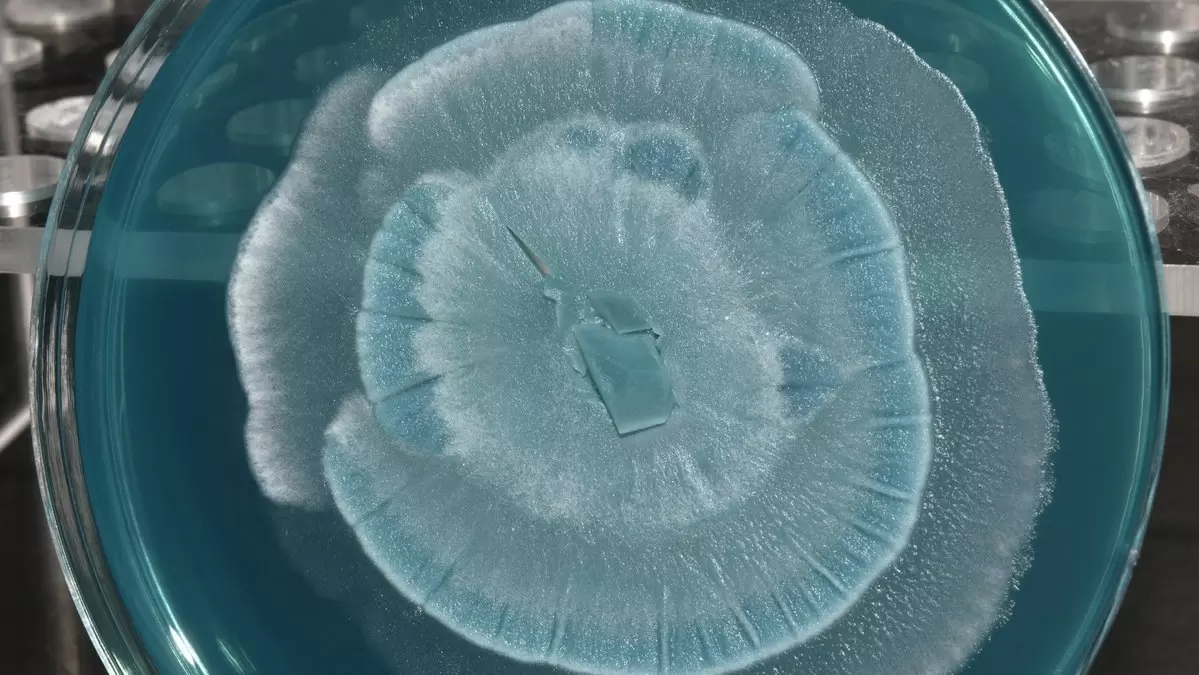

Недавние исследования показали, что удивительные белки, обнаруженные в грибах Mortierella, обладают способностью вызывать кристаллизацию воды при температурах чуть ниже нуля. Это открытие представляет собой потенциальный прорыв в таких областях, как управление погодой, хранение продуктов и криоконсервация.
Безопасная альтернатива для управления погодой
На протяжении десятилетий человечество применяет технологию засевания облаков для создания дождя. С самолетов в облака распыляют нуклеаторы, вокруг которых формируется лед. Эти кристаллы становятся тяжелыми, падают и, тая, превращаются в дождевые капли. Но традиционные нуклеаторы, такие как кристаллы йодида серебра, могут быть токсичными и негативно влиять на экологию. Грибной белок представляет собой безопасную альтернативу, способную значительно улучшить эту технологию.
Генетический прорыв в изучении грибов
Способность некоторых грибов образовывать лед была известна с начала 1990-х годов, однако только сейчас ученые смогли расшифровать геномы грибов семейства Mortierellaceae и выявить ген, отвечающий за синтез этих белков. Интересен тот факт, что этот ген, вероятно, был получен грибом от бактерии в ходе горизонтального переноса, что произошел сотни тысяч лет назад. Это редкий случай, подчеркивающий эволюционные связи между организмами.
Потенциал в криоконсервации и пищевой промышленности
Грибной белок, выделяющийся из клеток и растворяющийся в воде, дает значительное преимущество в различном применении. Например, его использование в пищевой промышленности позволяет избежать сложных компонентов, часто присутствующих в бактериальных нуклеаторах. Кроме того, это открытие имеет большие перспективы для криоконсервации. Добавление таких нуклеаторов может способствовать более мягкой заморозке клеток, что защищает их от повреждений.
Таким образом, это скромное открытие дает человечеству новые возможности для управления дождем, безопасного замораживания продуктов и клеток, открывая двери к инновационным методам в науке и промышленности.





























